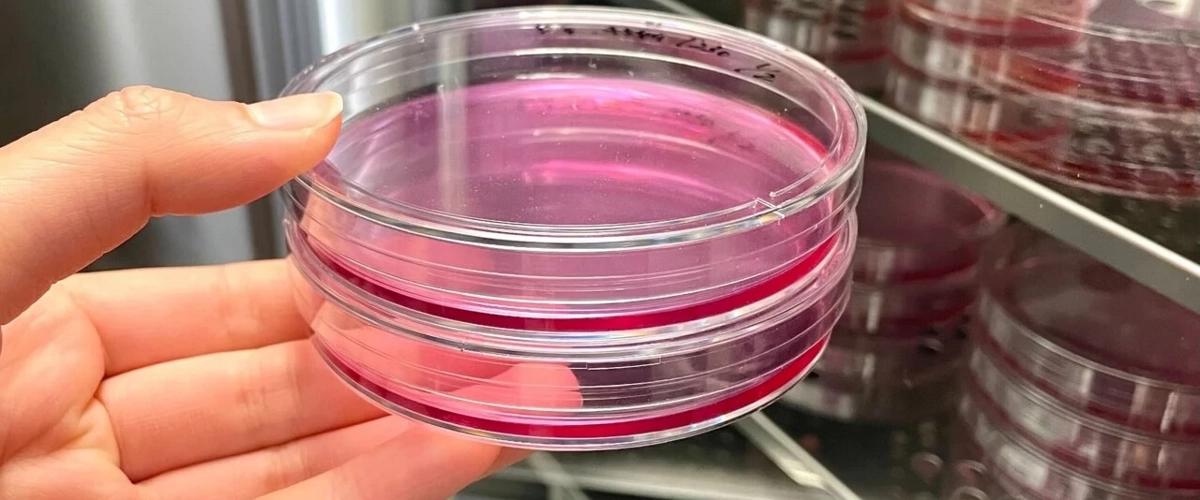
TODO:

Обычно клетки защищаются от вирусов через апоптоз — запрограммированную клеточную гибель, а также с помощью передачи сигналов белков интерферона. Между тем регуляторный механизм того, как клетки поддерживают баланс между апоптозом и реакцией интерферона для эффективного подавления репликации вируса во время инфекции оставался неясным.
Ученые знали, что некоторые растения и животные используют РНК-интерференцию (расщепление патогенной РНК) для подавления репликации вируса. Теперь ученые обнаружили белок TRBP, который регулирует механизм РНК-интерференции, пишет EurekAlert.
При этом участие TRBP наблюдется как при передаче сигналов интерферона, так и при апоптозе: TRBP увеличивает запрограммированную гибель инфицированных клеток, одновременно снижая передачу сигналов интерферона. Белок воздействует на клетку и полностью останавливает репликацию вируса, в отличие от пути реакции интерферона, который просто подавляет репликацию вируса, а не уничтожает инфицированные клетки.
Лучше понимая, как защита от вирусов работает на молекулярном уровне, исследователи рассчитывают на разработку лекарств на основе нуклеиновых кислот. Эта стратегия позволит повысить эффективность противовирусных препаратов, а также разработать новые лекарства против генетических заболеваний.
Недавно другие ученые представили стратегию для универсальной защиты от различных вирусов. Новый подход в создании вакцины использует воздействие на малые интерферирующие РНК, которые участвуют в иммунном ответе на вирусную инфекцию.